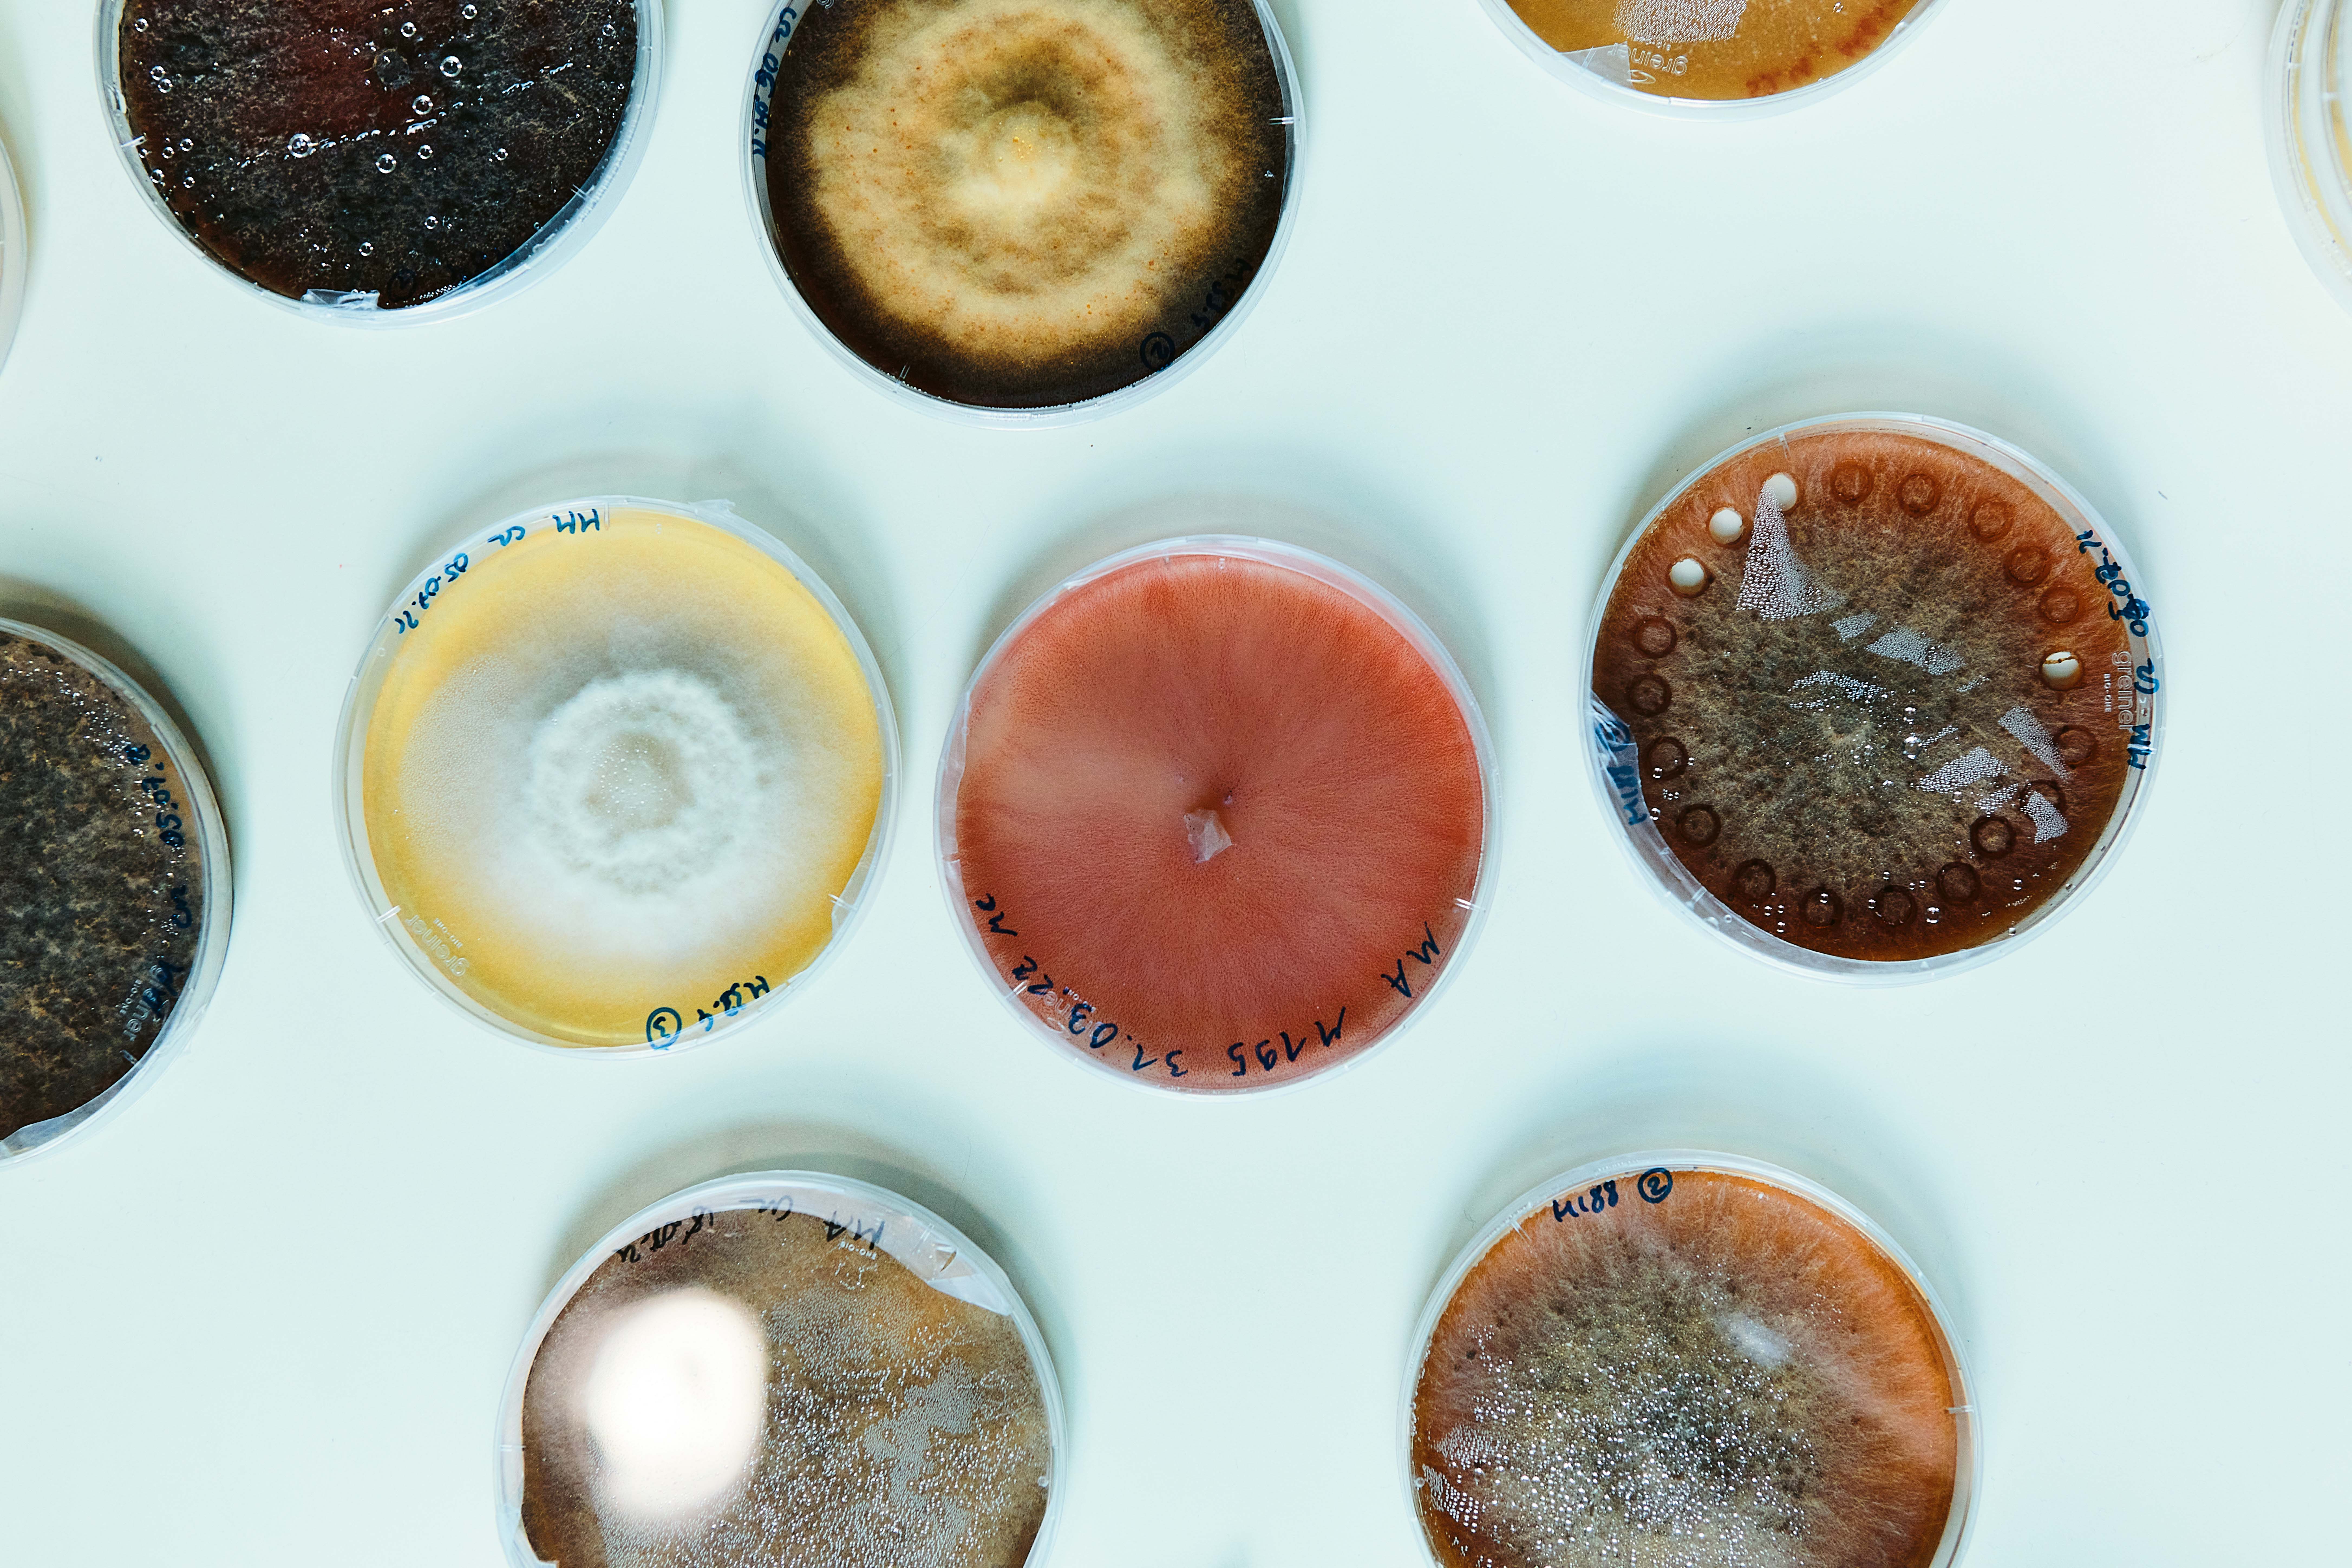
content-image
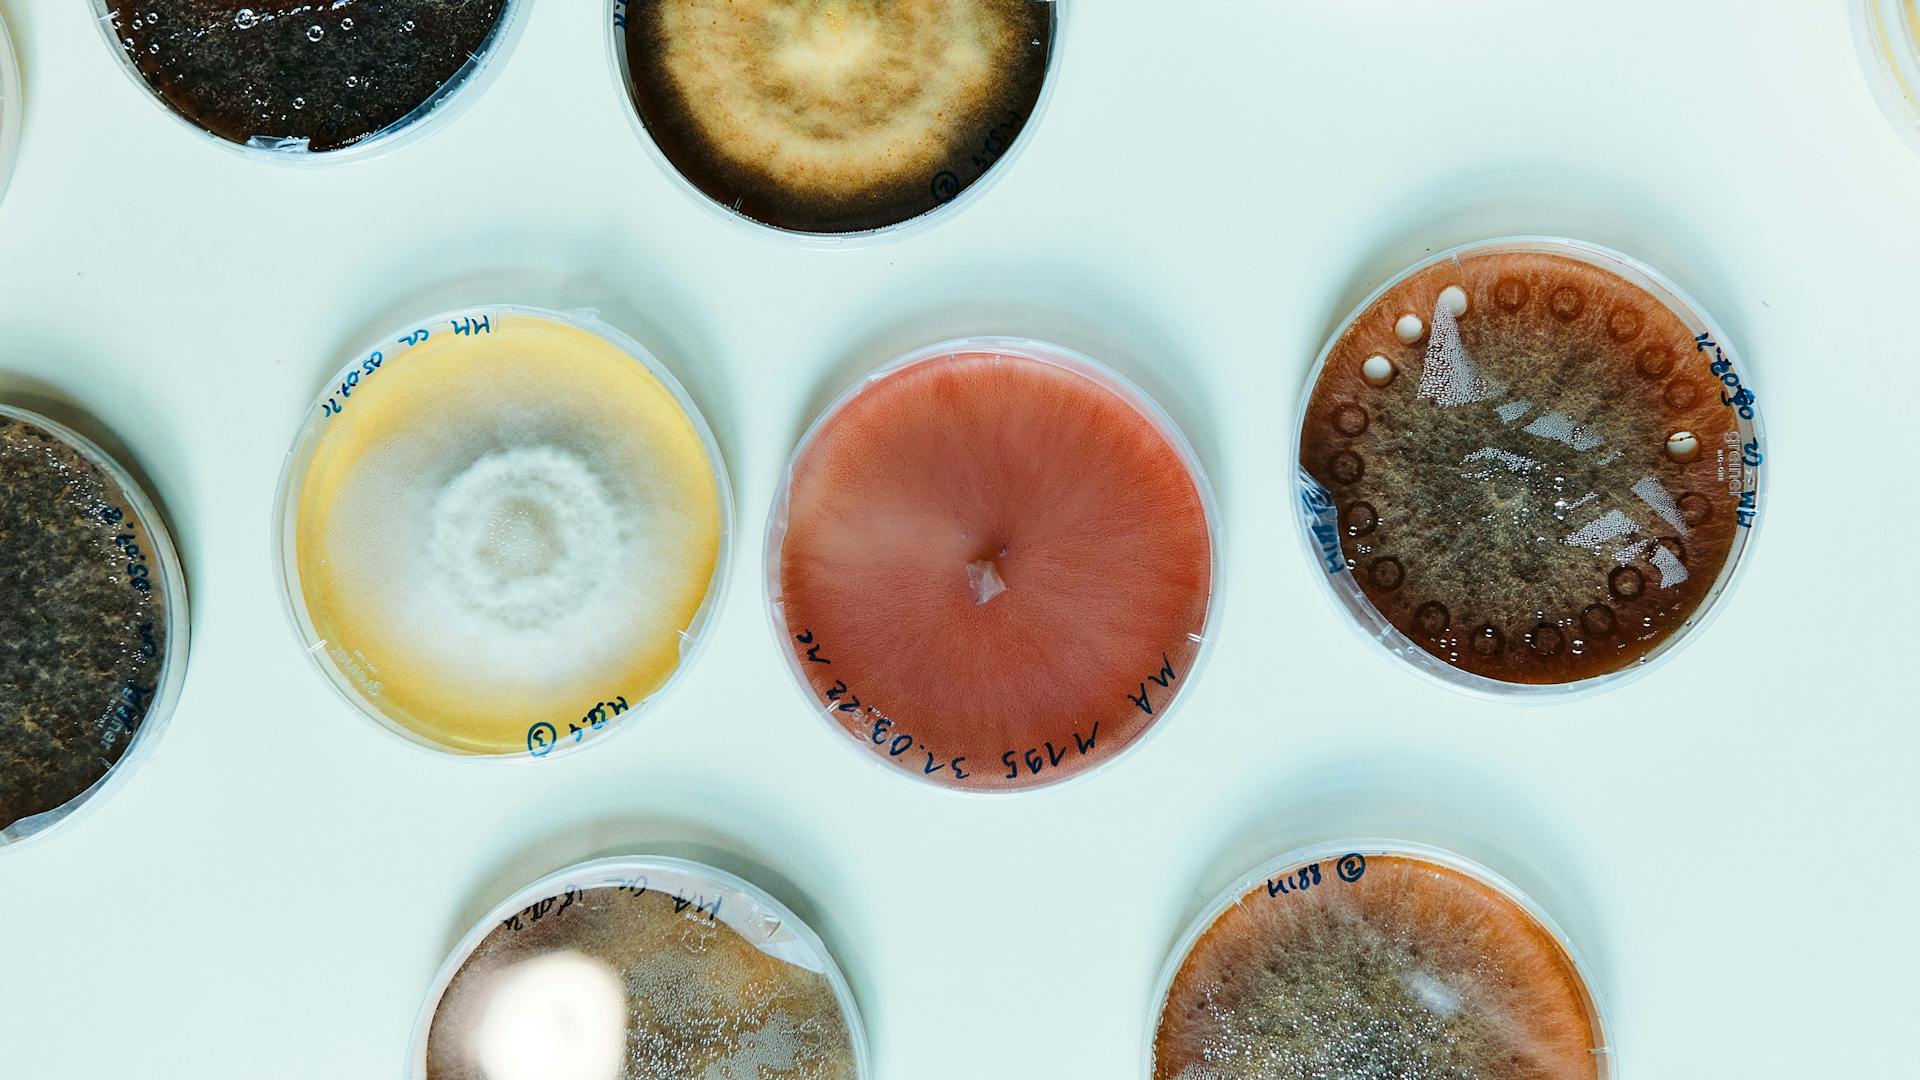
content-image
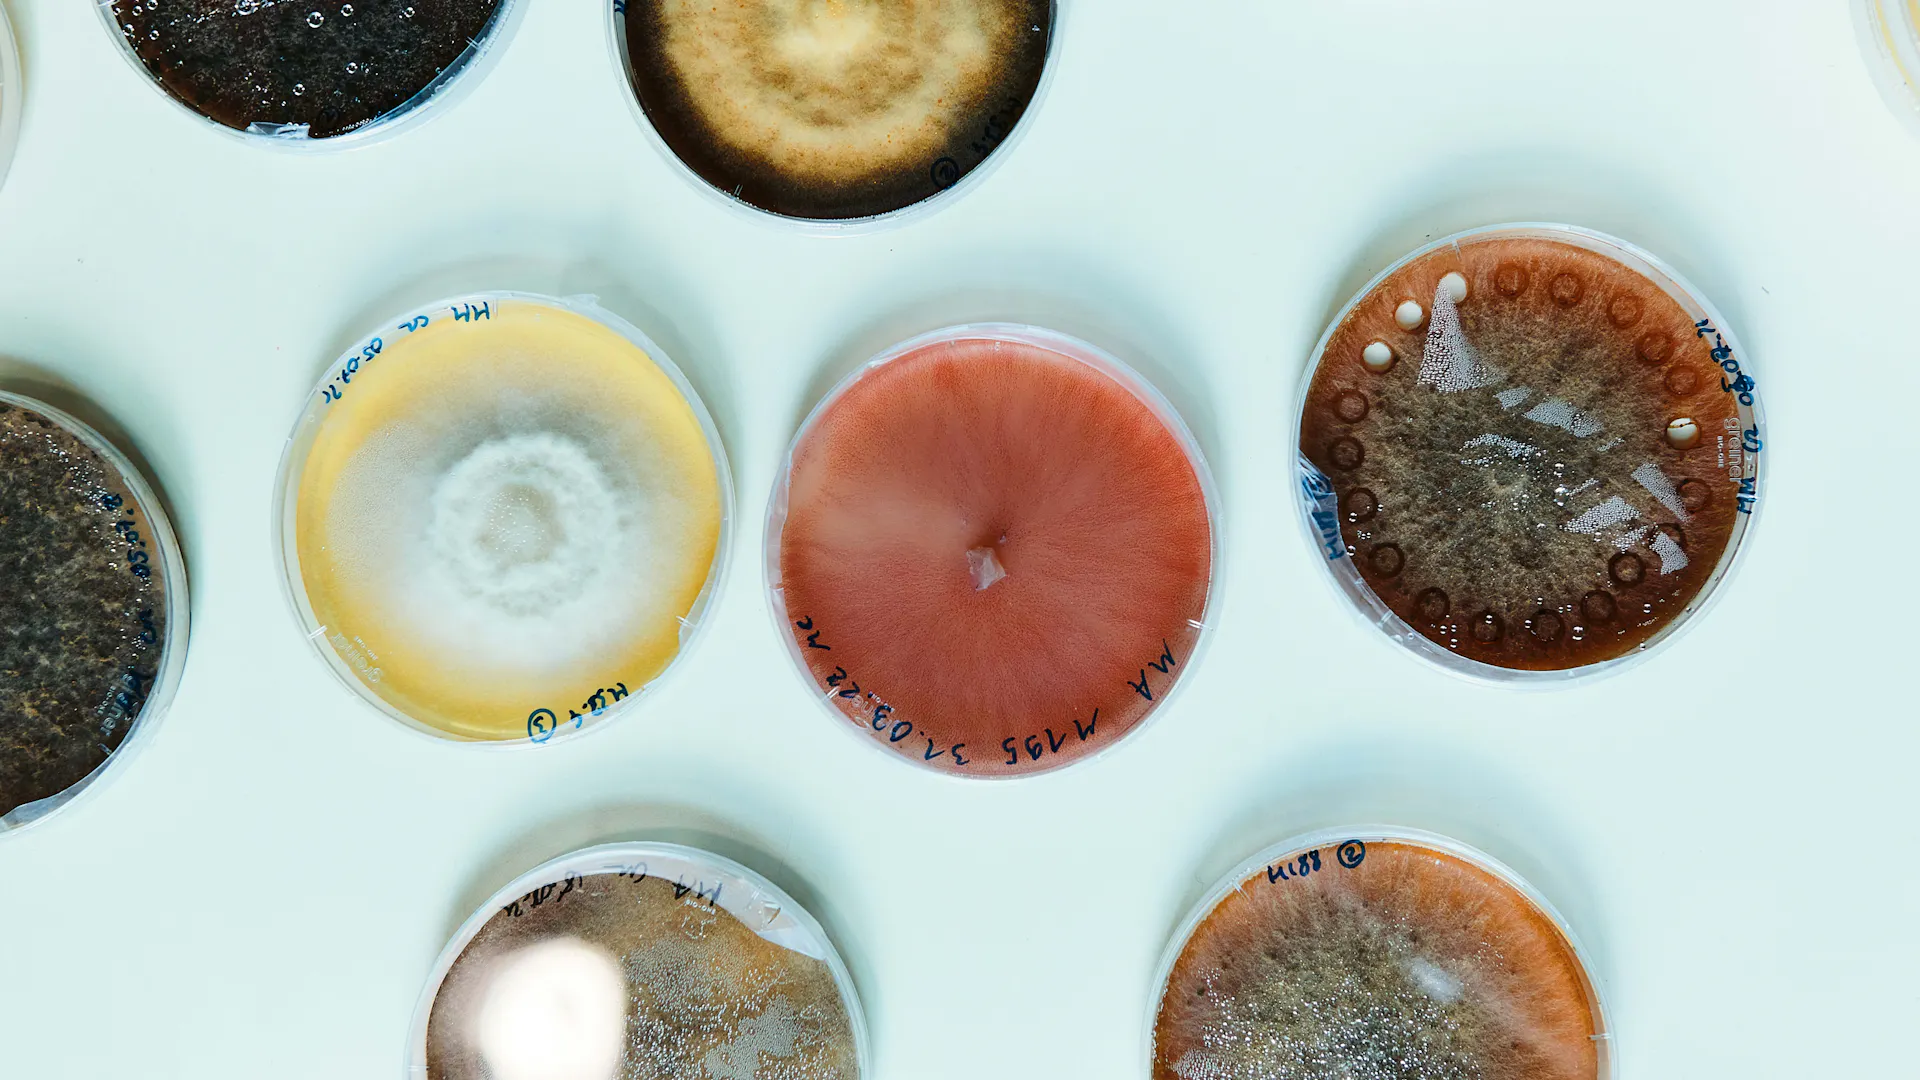

Publiziert am 01/08/2022
Liebe Leserin, lieber Leser
Mitte der 1990er-Jahre nahm die Globalisierung an Fahrt auf und ist seither aufgrund der verstärkten internationalen Zusammenarbeit, nicht zuletzt im Hochschulbereich, zur treibenden Kraft für das weltweite Wirtschaftswachstum und für die rasante technologische und wissenschaftliche Innovation geworden. Dies hat Millionen von Menschen weltweit aus der Armut befreit und ihnen einen besseren Zugang zur Gesundheitsversorgung ermöglicht.
Vor allem während der Coronakrise kam dieses globale Netzwerk zum Tragen und war mitentscheidend für die rasche Entwicklung und Verteilung innovativer Impfstoffe und Medikamente, die zur Eindämmung der Pandemie beitrugen. Doch schon vor dieser Gesundheitskrise waren wegweisende Technologien wie die künstliche Intelligenz und die Gentherapie das Ergebnis intensiver internationaler Teamarbeit.
Die Schweiz hat von diesem Trend profitiert und diesen auch vorangetrieben. Das Land konnte in den vergangenen 30 Jahren seine Position als eine der reichsten Volkswirtschaften der Welt festigen. Darüber hinaus hat sich die Schweiz zu einem Innovations-Spitzenreiter entwickelt. Hier sind, um nur einige wenige Beispiele zu nennen, weltweit führende Forschungseinrichtungen wie die Europäische Organisation für Kernforschung, CERN, und das Paul-Scherrer-Institut angesiedelt.
Allerdings weist dieses Bild Risse auf, und zwar aufgrund zunehmender geopolitischer Spannungen und der Tatsache, dass die akademischen Zentren der Schweiz den vollen Zugang zum EU-Forschungsprogramm Horizon Europe mit einem Volumen von 95,5 Milliarden Euro verloren haben. Dennoch bleibt die internationale Zusammenarbeit weiterhin ein Kernstück der Wissenschaft und der Wirtschaft des Landes.
Zürich, Lausanne und Basel zählen mit ihren engmaschigen Forschungsnetzwerken aus Universitäten, privaten Forschungsinstituten, einer lebendigen Start-up-Szene und führenden Pharmaunternehmen wie Roche und Novartis nach wie vor zu den weltweit innovativsten Forschungsstandorten. Sie können sich mit den Besten messen und schaffen es auch, neue Partner ausserhalb Europas zu finden.
Die Beschleunigung von Kooperationen ist daher auch in diesen immer schwierigeren Zeiten unerlässlich. Als wissenschaftsbasiertes Unternehmen betrachtet Novartis die Zusammenarbeit als wesentliches Element ihrer Innovationsbemühungen. Dazu gehört die externe Zusammenarbeit mit Fachleuten aus Industrie und Wissenschaft, aber auch die Kooperation mit Anspruchsgruppen wie etwa Patientenorganisationen und NGOs.
Da es immer wichtiger wird, sich mit anderen zu vernetzen, haben wir unseren Campus in Basel auch für andere Unternehmen geöffnet, um den Forschungsstandort der Region zu stärken und die Kooperation mit hochspezialisierten Start-up-Unternehmen zu intensivieren. Wir fördern auch bereits vorhandene Partnerschaften mit Akteuren wie dem Friedrich Miescher Institute for Biomedical Research, das demnächst auf unseren Campus ziehen wird.
Wie diese Ausgabe des live-Magazins zeigt, haben wir in den vergangenen Jahren in der Schweiz neue Förderprogramme wie etwa FreeNovation zur Finanzierung von unkonventionellen Forschungsprojekten ins Leben gerufen. Darüber hinaus haben wir gemeinsam mit der Universität Basel und dem Universitätsspital Basel das Institut für Molekulare and Klinische Ophthalmologie Basel mitbegründet.
Intern fördern wir zudem unser Genesis-Labs-Programm, das es unseren Wissenschaftlerinnen und Wissenschaftlern ermöglicht, innovative Projekte durchzuführen, die ausserhalb unserer Kernbereiche liegen. Eines dieser Projekte ist jetzt ein Kernstück der Innovative Medicines Initiative, IMI, der weltweit grössten öffentlich-privaten Partnerschaft im Bereich Life Sciences.
Damit die Schweiz auch in Zukunft ein Ort naturwissenschaftlicher Spitzenleistungen bleibt und mit anderen führenden Forschungszentren in den USA, Asien und Europa Schritt halten kann, muss die wissenschaftliche Gemeinschaft der Schweiz offen für neue Möglichkeiten bleiben und mutig nach vorne schauen, wenn es darum geht, neue Forschungsansätze zu entwickeln, die anderswo nicht verfolgt werden.
Herausfordernde Zeiten bieten immer auch neue Chancen. Die Schweiz hat immer wieder bewiesen, dass sie mit Krisen umgehen kann. Doch ein Land, das mehr als 20 Nobelpreisträgerinnen und Nobelpreisträger hervorgebracht hat, sollte nicht nur zurückblicken. Das Vermächtnis des Landes sollte auch ein Motor sein, um couragiert voranzuschreiten und künftig das zu tun, was es am besten kann: Innovationen schaffen und sich mit der Welt verbinden. Wir bei Novartis werden unsere Arbeit in diesem Sinne fortsetzen.
Jörg Reinhardt
Präsident des Verwaltungsrats
"Hier Live. N°11 als PDF downloaden!"
Vielen Dank für das Lesen des Live Magazins
Bleiben Sie auf dem Laufenden, indem Sie unseren Newsletter abonnieren.
AbonnierenMit dem Absenden Ihrer E-Mail erklären Sie sich damit einverstanden, dass die Novartis AG Ihre E-Mail-Daten für den internen Gebrauch von Novartis, in Übereinstimmung mit unserer Datenschutzrichtlinie und mit geschützten technischen Mitteln erfasst und verarbeitet.